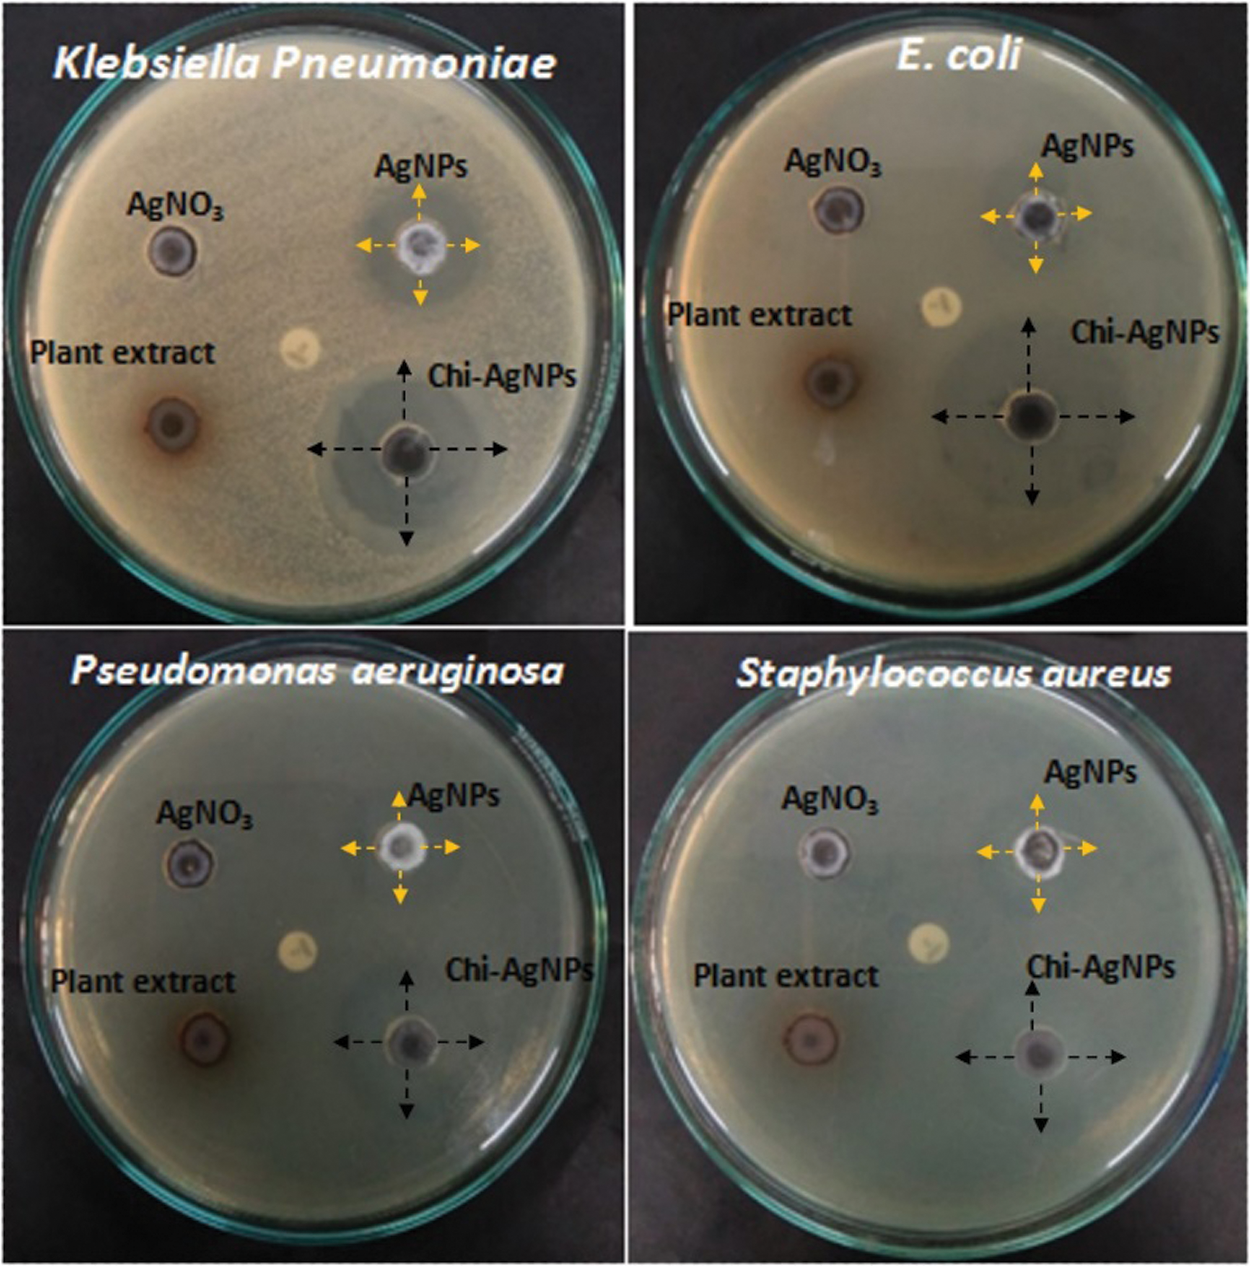
images

![]() | Journal of Renewable Materials | ![]() |
DOI: 10.32604/jrm.2022.019335
ARTICLE
Synthesis, Characterization and Remedial Action of Biogenic Silver Nanoparticles and Chitosan-Silver Nanoparticles against Bacterial Pathogens
1Department of Life Sciences, School of Basic Sciences and Research, Sharda University, Greater Noida, 201310, Uttar Pradesh, India
2Viyen Biotech LLP, Coimbatore, Tamil Nadu, 641031, India
3Department of Biotechnology, Kongunadu Arts and Science College, Coimbatore, Tamil Nadu, 641029, India
4Department of Biotechnology, Graphic Era Deemed to be University, Dehradun, Uttarakhand, 248002, India
5Department of Clinical Laboratories Sciences, The Faculty of Applied Medical Sciences, Taif University, Taif, 21944, Saudi Arabia
6Biorefining and Advanced Materials Research Center, SRUC, Edinburgh, EH9 3JG, UK
7Department of Mechanical Engineering, School of Engineering, Shiv Nadar University, Noida, Greater Noida, 201314, India
8School of Engineering, University of Petroleum & Energy Studies (UPES), Dehradun, Uttarakhand, 248007, India
*Corresponding Authors: R. Ranjithkumar. Email: biotechranjith@gmail.com; Vijay Kumar Thakur. Email: Vijay.Thakur@sruc.ac.uk
Received: 17 September 2021; Accepted: 08 November 2021
Abstract: Custard apple is a dry land fruit. Its leaves exhibit different pharmacological activities. In the present study, both silver (Ag) nanoparticles and chitosan-coated Ag (Chi-Ag) nanoparticles were fabricated using the aqueous leaf extract of the custard apple plant. During preliminary phytochemical analysis, various types of phytocompounds were found in the aqueous leaf extract of the same plant. Next, both nanoparticles were physiochemically characterized. FTIR analysis exhibited the fingerprint vibrational peaks of active bioactive compounds in plant extract, Ag nanoparticles, and Chi-Ag nanoparticles. UV/Visible spectral analysis revealed the highest absorbance peak at 419 nm, indicating the presence of Ag nanoparticles. XRD analysis presented the face-centered cubic (FCC) structure of both prepared nanomaterials. Further, the average crystalline size of both Ag nanoparticles and Chi-Ag nanoparticles was calculated to be 23 and 74 nm, respectively. FESEM analysis showed the spherical and cubical shapes of Ag nanoparticles and Chi-Ag nanoparticles, respectively. EDS analysis indicated a peak around 3.29 keV, conforming to the binding energies of Ag ions. The biogenic nanomaterial also showed strong antibacterial activity against all tested bacterial pathogens.
Keywords: Custard apple; chitosan; Ag nanoparticles; Chi-Ag nanoparticles; antibacterial
In recent years, the field of nanoscience has grown, and we have explored several nanomaterials in numerous biomedical, agricultural, and sensing applications [1]. In general, the synthesis of inorganic and organic nanoparticles with uniform size distribution and controlled monodispersity is a significant area of research in nanotechnology. Among inorganic nanoparticles, metal and metal-oxide nanoparticles play a significant role in having larger surface areas and more fractionally surface atoms because of their exceptional physicochemical properties [2–6]. Due to this, they become excellent materials for biomedical applications.
Polymers form an important class of materials and are classified into three types: natural polymer, synthetic polymer, and semi-synthetic polymer. Among these polymers, Chitosan is a natural amino polysaccharide having a unique structure with multidimensional properties. It has a wide range of applications in the biomedical field due to its excellent biocompatibility, biodegradability, low immunogenicity, and good antimicrobial activity [7–11]. The physicochemical properties of chitosan polymer were further improved by fabricating their composites. The polymer composites are hybrid nanomaterials in which Polymers coated nanoparticles and a core-shell structure can be created [12–14]. Therefore, the metal nanoparticles coated with chitosan polymer into a single “hybrid” nanosystem give good physicochemical and biological properties [15–18].
Over the past decades, various metals (e.g., Au, Ce, Cu, Pt, Zn, Ce, Cd, Fe, Al, Ti, Ni, Co, Br, etc.) have been brought to nm size with various dimensions and morphologies using multiple experimental techniques for diverse applications. Among these nanoparticles, silver is one of the most preferred metal choices due to its elegant applications in the biomedical field [19]. Many methods are implemented for the preparation of nanoparticles, including chemical, physical, and biological processes. The physical and chemical methods are not generally environmentally friendly in nature. They have some disadvantages such as toxic chemicals, involvement of expensive instruments (PVD, CVD, Laser, high beam, etc.), which lead to high cost, the requirement of high energy and pressure. Biological mediated nanoparticle synthesis is gaining importance since this process is non-toxic, biocompatible, and eco-friendly [20–22].
The use of plants for nanoparticle biosynthesis is an exciting possibility that needs to be explored more. The foremost benefit of the plant (leaf, root, stem, seed, peel, flower, etc.) extract mediated synthesis of nanoparticles is that they are safe and non-toxic in most cases due to the presence of different medicinally essential phytochemicals that can aid the stabilize and reduction of metal ions to metallic nanoparticles, also readily available and low cost (Scheme 1) [23]. In 2020, Renuka et al., used the fruit extract of the Phyllanthus emblica plant to synthesize silver nanoparticles, which exhibited strong antibacterial properties against Klebsiella pneumoniae and Staphylococcus aureus [24].

Scheme 1: The diagram shows the formation of biogenic Ag nanoparticles using the custard apple plant leaf extract (Annona squamosa L.)
Annona squamosa L. (Family-Annonaceae), also known as “custard apple” is a tropical endemic species. The leaf, root, fruit, peel, stem, and seed extracts of this plant have been utilized in traditional pharmacological applications [25–27]. This study demonstrated the biosynthesis of custard apple’s leaf extract mediated silver, and chitosan-coated silver nanoparticles. Further, we have given in detail the physicochemical properties of these nanoparticles and showed their antibacterial properties against human bacterial pathogens.
The silver nitrate and chitosan were obtained from Himedia, India. The organic solvents were procured from Merck, USA, and all the glasswares were obtained from Borosil, India.
2.2 Preparation of the Plant Extract and Preliminary Phytochemical Screening
The leaves of the custard apple plant were rinsed with distilled water to remove the attached dust particles and dried. The preparation of aqueous leaf extract was initiated by taking 10 g of powdered leaf in 100 mL distilled water and boiling for the next 20 min. The crude solution was left to cool at room temperature. Next, the prepared leaf extract was filtered using Whatman filter paper no. 1, and the collected leaf extract was stored at 4°C for further preliminary phytochemical screening. The presence of saponins, alkaloids, phenols, flavonoids, tannins, and glycosides in the aqueous leaf extract was determined through standard protocols [28,29].
2.3 Fabrication of Ag Nanoparticles and Chi-Ag Nanoparticles
Initially, a 1 mM aqueous solution of silver nitrate was prepared. Then, 20 mL of prepared aqueous leaf extract was added to the reaction mixture. The pH of the resulting solution was calculated to be 7.0. Then, the solution was kept for the subsequent 24 h incubation at room temperature. After incubation, the brown colour of the reaction mixture was obtained, indicating the fabrication of Ag nanoparticles via one-pot green synthesis method. The prepared solution was centrifuged for 20 min at 10,000 rpm and the obtained pellet was dried at 60°C to get the final product. Also, the reduction of Ag ions in aqueous leaf extract solution was monitored through UV/Visible spectroscopy (Data not shown).
Next, 0.2 g chitosan was dissolved in a 10 mL solution of 2% glacial acetic acid. Then, Ag nanoparticles solution was added dropwise until 2 h and left for 24 h in a dark room. The reaction mixture was centrifuged, and the obtained pellet was dried at 40°C for 3 h and finally stored at room temperature.
2.4 Physicochemical Characterizations of Ag Nanoparticles and Chi-Ag Nanoparticles
Different physicochemical techniques characterized both nanoparticles. FTIR spectroscopy was used to investigate the bonding linkage of fabricated nanoparticles with the functional groups of various bioactive compounds present in the custard apple leaf extract through bridging linkage. The vibrational peaks were recorded by Shimadzu FTIR spectrometer in the wavenumber region of 450–4000 cm−1. Next, an X-ray diffractometer (PAN analytical BV) was used to measure the diffraction pattern of both nanoparticles in the diffraction angle range of 10°–80°. The surface morphology and particle size of Ag nanoparticles and Chi-Ag nanoparticles were analyzed by Field-Emission Scanning Electron Microscopy (HITACHI SU6000 FESEM). Furthermore, the chemical composition of the prepared nanomaterial was studied through HITACHI SU6000 SEM equipped with an EDX attachment.
The antibacterial properties of Ag nanoparticles and Chi-Ag nanoparticles were examined against human pathogenic bacterial by standard well diffusion technique. The inoculum of tested bacteria was prepared by growing pure isolates in nutrient broth at 37°C for overnight. The agar plates were prepared by the pour plate method using MHA medium. 1 mL of bacterial culture was poured and swabbed into the sterile Petri-dishes and left the bacteria to grow. About 30 µL of prepared 1 mg/mL concentrations of plant extract, AgNO3, Ag nanoparticles, and Chi-Ag nanoparticles was added to each well to find their antibacterial properties. The assay plates were further incubated at 37°C for 24 h, and the observed zone of inhibition was measured.
The preliminary phytochemical screening of the aqueous leaf extract of the custard apple plant is represented in Table 1. We observed the presence of alkaloids, flavonoids, saponins, carbohydrates, glycosides, phenols, proteins, and tannins in the leaf extract. Such secondary metabolites in the plant are responsible for different pharmacological actions [30–33].

3.2 Biogenic Synthesis of Ag Nanoparticles and Chi-Ag Nanoparticles
In this study, we carried out the biogenic synthesis of Ag nanoparticles using custard apple aqueous leaf extract. We added 1 mM AgNO3 in leaf extract solution then the colour of the reaction mixture was changed from yellow to brown which indicated the reduction of Ag+ ions and formation of Ag nanoparticles. The reduction of Ag+ ions was analyzed using a UV-visible spectrophotometer. We observed a strong peak at 419 nm (Fig. 1), and this peak provides a convenient surface plasmon resonance signature for the formation of Ag nanoparticles [34,35]. Further, the chitosan was coated on the surface of Ag nanoparticles, forming Chi-Ag nanoparticles.

Figure 1: UV-Visible spectrum of biogenic Ag nanoparticles in the wavelength range of 390–800 nm
Different techniques physicochemically characterized the fabricated Ag nanoparticles and Chi-Ag nanoparticles. FTIR spectrum of aqueous leaf extract of custard apple plant, Ag nanoparticles, and Chi-Ag nanoparticles was displayed in Fig. 2. The plant extract presented several peaks indicating their complex compositions. The bands appearing at 3365.14 cm−1, 1814.09 cm−1, 1634.64 cm−1, 1327.03 cm−1, 1026.13 cm−1, and 678.94 cm−1 were assigned to O-H, C=O, C=C, and C-N functional groups of alcohol, phenol, hydroxyl, amine, carboxylic acids, and halo compounds. However, the biogenic Ag nanoparticles showed a shift in the peaks at 3672.47 cm−1, 3340.71 cm−1, 2885.51 cm−1, 1728.22 cm−1, 1519.91 cm−1, 1327.03 cm−1, and 817.82 cm−1, which were assigned to N-H, O-H, C-H, C=C, C=O, and N-O functional groups of alcohol, secondary amine, alkaline, aldehydes, and alkene. In addition, the Chi-Ag nanoparticles displayed the absorbance peaks at 3039.81 cm−1, 2059.98 cm−1, 1743.65 cm−1, 1597.06 cm−1, 1512.19 cm−1, 1334.74 cm−1, 1211.30 cm−1, 887.26 cm−1, and 810.10 cm−1 that were given to O-H, N=C=N, C=O, N=H, N-O, C-O, and C-C functional groups of phenol, alcohol, amine, nitro compound, and alkene.

Figure 2: FTIR spectrum of aqueous leaf extract of custard apple plant, Ag nanoparticles, and Chi-Ag nanoparticles in the wavenumber range of 450–4000 cm−1
These results confirmed the presence of phenols, hydroxyl, and carboxylic acid groups derived from the aqueous leaf extract of the custard apple plant. Hence, the FTIR spectrum indicated the presence of different functional groups such as phenols, hydroxyl, and carboxylic acids that are being capped on the surface of the prepared Ag nanoparticles. The bonding vibration of C-N and C-O indicates the presence of amine and carboxylic groups in prepared Chi-Ag nanoparticles, which may be due to chitosan polymer (C56H103N9O39), which clearly indicated the prepared Ag nanoparticles are conjugated with the chitosan. The plant-derived phytocompounds and chitosan lead to the reduction, formation, and surface coating of Ag nanoparticles and Chi-Ag nanoparticles where various functional groups lead to the different applications of prepared bionanomaterials [36–38].
3.4 X-Ray Diffraction Analysis
The XRD patterns of Ag nanoparticles and Chi-Ag nanoparticles were exposed in Fig. 3. We observed the major and minor diffraction peaks conforming to the Miller indices [hkl] of silver and silver oxide (100, 110, 111, 200, 211, 211, 220, 310, and 311). This confirmed the FCC configuration of Ag nanoparticles [39]. The XRD spectrum of both samples showed two different phases of silver and silver oxide. The peaks obtained at 2Θ = 27.81°, 32.20°, 54.85°, 57.49°, and 76.77° that presented to the Miller indices [hkl] of silver oxide (100, 110, 211, 211, and 310) matching with JCPDS file no. 00-076-1393 [40,41] while the peaks at 2Θ = 38.44°, 46.54°, 64.73°, 76.93°, and 77.66° representing the Miller indices [hkl] of silver (111, 200, 220 and 311) matching with JCPDS file no. 04-0783 [42,43]. The prepared samples showed two peaks around 44.51° and 74.76° in the XRD spectrum due to the crystallization phase of phytochemicals [44,45]. Furthermore, the Scherrer equation calculated the average crystallite size of Ag nanoparticles, which was 23 and 74 nm from the breadth of (110 and 111) reflection [46]. In earlier reported studies, the silver oxide nanoparticles are further reduced to silver nanoparticles [47,48].

Figure 3: XRD patterns of Ag nanoparticles and Chi-Ag nanoparticles in the diffraction range of 10°–80°
FE-SEM determined the surface morphologies of Ag nanoparticles and Chi-Ag nanoparticles. We showed the uniform spherical shape of Ag nanoparticles. Next, the average particle size of Ag nanoparticles was calculated to be 38.99 nm using their particle size distribution curve (data not shown). These nanoparticles were also showing high agglomeration and clustering of Ag nanoparticles that may be attributed to the interaction between phytocompounds present in the custard apple leaf extract and nanoparticles (Fig. 4). However, the Chi-Ag nanoparticles presented their uniform cubical shape with an average particle size of 241.82 nm and the obtained results indicated that the surface of the nanoparticles was successfully capped by the polymeric structure of chitosan (Fig. 4). The rationale behind the high agglomeration of Ag nanoparticles can be due to different types of capping agents present in the aqueous leaf extract of the custard apple plant.

Figure 4: FESEM images of Ag nanoparticles (Upper panel) and Chi-Ag nanoparticles (Lower panel)
In our study, the elemental analysis of prepared Ag nanoparticles and Chi-Ag nanoparticles was performed using their corresponding EDS spectrum. We showed the determined peaks around 3.29 keV conforming to the binding energies of Ag ions (Fig. 5). Furthermore, the Chi-Ag nanoparticles showed an absorbance peak of nitrogen (N) in its EDS spectrum; it may have come from the amine (-NH2) group of chitosan (C56H103N9O39), which indicates the excitation of X-ray from polymer. Further, other peaks in the EDS spectrum suggest mixed precipitates present in the prepared plant extract [49].

Figure 5: EDS spectrum of Ag nanoparticles (Upper panel) and Chi-Ag nanoparticles (Lower panel)
The antibacterial properties of both Ag nanoparticles and Chi-Ag nanoparticles were investigated against different human bacterial pathogens. We observed that both nanoparticles presented significant antibacterial activity against chosen human bacterial pathogens (Fig. 6).
Figure 6: Antibacterial activity of custard apple plant’s leaf extract, Ag nanoparticles, and Chi-Ag nanoparticles against different bacterial pathogens
In this test, Chi-Ag nanoparticles showed the maximum zone of inhibition (ZoI) against E. coli (21 mm) followed by Klebsiella pneumoniae (18 mm), Staphylococcus aureus (17 mm), and Pseudomonas aeruginosa (16 mm). On the other hand, biogenic synthesis Ag nanoparticles showed significant antibacterial activity against E. coli (17 mm) and Klebsiella pneumoniae (13 mm). These Ag nanoparticles also exhibited moderate antibacterial action against Staphylococcus aureus (9 mm) and Pseudomonas aeruginosa (8 mm). However, the aqueous leaf extract of custard apple and the positive control solution 1 mM AgNO3 displayed the minimum antibacterial activity around 0.8 to 1 mm against all chosen bacterial pathogens. Thereby, the prepared hybrid Chi-Ag nanoparticles showed higher antibacterial properties against all tested bacterial pathogens compared to crude leaf extract and Ag nanoparticles. In a study, Klueh et al., reported that the positively charged Ag ions play a vital role in the antibacterial properties of Ag nanoparticles. In addition, the electrostatic attraction between the positively charged nanoparticles and negatively charged bacterial cells also leads to the antibacterial activity of nanoparticles [50,51]. In some studies, it was reported that the antibacterial property of nanoparticles mostly depends upon the shape, size, ionic strength of the medium, and type of capping agent present on the surface of nanoparticles. Nevertheless, the explicit antibacterial mechanisms of the nanoparticles have not been completely explained. Further, based on the other reports, it was suggested that the antibacterial and anticancer effects of the nanomaterials and nanocomposites can involve many possible mechanisms (Fig. 7), for example—cell-surface membrane interaction, formation of free radicals inside the bacterial or cancer cell, inhibition of enzyme activities, inhibition of cell wall synthesis, ribosome disassembly followed by the inactivation of protein synthesis and structure modification of essential proteins, interface with cell signaling and incorporation into the DNA bases to DNA damage [52–56]. Based on this literature, our present study clearly indicates that the Chi-Ag nanoparticles showed the potential antibacterial property, and it will be useful for the treatment and management of various microbial infections.

Figure 7: Possible mechanisms of the antibacterial activity of nanoparticles [56]
In this present study, we used the aqueous leaf extract of the custard apple plant as a reducing agent to prepare Ag nanoparticles. In preliminary phytochemical screening, the crude aqueous leaf extract showed the occurrence of flavonoids, alkaloids, saponins, carbohydrates, glycosides, phenols, proteins, and tannins that could reduce Ag+. In the UV/Visible spectrum, an absorbance peak was observed at 419 nm, indicating the formation of Ag nanoparticles. In general, chitosan and its derivatives have been widely used in different biomedical applications. We further prepared Chi-Ag nanoparticles to enhance the biomedical properties of Ag nanoparticles. The crystal size, surface morphology, elemental composition, and functional molecular analysis of prepared Ag nanoparticles and Chi-Ag nanoparticles were investigated with XRD, FESEM, EDS, and FTIR spectroscopy. XRD spectrum indicated the presence of organic constituents and Ag nanoparticles, which was again confirmed by FTIR analysis. The calculated crystallite size of Ag nanoparticles and Chi-Ag nanoparticles was calculated to be 23 and 74 nm, respectively. FESEM analysis showed the spherical shape of Ag nanoparticles and the cubical shape of Chi-Ag nanoparticles. Furthermore, the Chi-Ag nanoparticles showed strong antibacterial activity against tested bacterial pathogens like S. aureus, E. coli, K. pneumoniae, and P. aeruginosa. Next, the Ag nanoparticles showed a moderate antibacterial effect followed by custard apple leaf extract. Hence, the present study concludes that the biopolymer-coated metal nanoparticles can open new avenues in various biomedical applications.
Acknowledgement: The authors gratefully acknowledge CNR RAO Research Center, Avinasilingam Institute for Home Science and Higher Education for Women for the XRD, EDS, FESEM and FTIR analysis.
Funding Statement: The authors would like to thank Department of Science and Technology (DST-FIST), India for the grants provided (Grant No. DST-FIST/120/2012) to establish laboratory facilities at Department of Biotechnology, Kongunadu Arts and Science College, Coimbatore, Tamilnadu, India. Dr. Piyush Kumar Gupta is thankful to the Department of Life Sciences, School of Basic Sciences and Research, Sharda University for providing the infrastructure and facility. Walaa F. Alsanie would like to acknowledge Taif University TURSP Program (TURSP-2020/53) for funding. Vijay Kumar Thakur would also like to thank the research support provided by the Royal Academy of Engineering (IAPP18-19\295), and UKIERI (DST/INT/UK/P-164/2017).
Conflicts of Interest: The authors declare that they have no conflicts of interest to report regarding the present study.
1. Dimkpa, C. O., Bindraban, P. S. (2018). Nanofertilizers: New products for the industry. Journal of Agricultural and Food Chemistry, 66(26), 6462–6473. DOI 10.1021/acs.jafc.7b02150. [Google Scholar] [CrossRef]
2. Kaushik, N., Thakkar, M. S., Snehit, S., Mhatre, M. S., Rasesh, Y. et al. (2010). Biological synthesis of metallic nanoparticles. Nanomedicine: Nanotechnology, Biology and Medicine, 6(2), 257–262. DOI 10.1016/j.nano.2009.07.002. [Google Scholar] [CrossRef]
3. Wang, L., Li, Y., Zhang, Y., Gu, H., Chen, W. (2014). Rare earth compound nanowires: Synthesis, properties and applications. Journal of Nanoscience and Nanotechnology, 3(1), 1–19. DOI 10.1166/rnn.2014.1041. [Google Scholar] [CrossRef]
4. Mou, X., Ali, Z., Li, S., He, N. (2015). Applications of magnetic nanoparticles in targeted drug delivery system. Journal of Nanoscience and Nanotechnology, 15(1), 54–62. DOI 10.1166/jnn.2015.9585. [Google Scholar] [CrossRef]
5. Zhang, D., Ma, X. L., Gu, Y., Huang, H., Zhang, G. W. (2020). Green synthesis of metallic nanoparticles and their potential applications to treat cancer. Frontiers in Chemistry, 8, 1231. DOI 10.3389/fchem.2020.00799. [Google Scholar] [CrossRef]
6. Orel, V., Shevchenko, A., Romanov, A., Tselepi, M., Mitrelias, T. et al. (2015). Magnetic properties and antitumor effect of nanocomplexes of iron oxide and doxorubicin. Nanomedicine, 11(1), 47–55. DOI 10.1016/j.nano.2014.07.007. [Google Scholar] [CrossRef]
7. Vakili, M., Rafatullah, M., Salamatinia, B., Abdullah, A. Z., Ibrahim, M. H. et al. (2014). Application of chitosan and its derivatives as adsorbents for dye removal from water and wastewater: A review. Carbohydrate Polymers, 113(11), 115–130. DOI 10.1016/j.carbpol.2014.07.007. [Google Scholar] [CrossRef]
8. Hamed, I., Ozogul, F., Regenstein, J. M. (2016). Industrial applications of crustacean by-products (chitin, chitosan, and chitooligosaccharidesA review. Trends in Food Science & Technology, 48(1), 40–50. DOI 10.1016/j.tifs.2015.11.007. [Google Scholar] [CrossRef]
9. Ahmad, A., Mubharak, N. M., Naseem, K., Tabassum, H., Rizwan, M. et al. (2020). Recent advancement and development of chitin and chitosan-based nanocomposite for drug delivery: Critical approach to clinical research. Arabian Journal of Chemistry, 13(12), 8935–8964. DOI 10.1016/j.arabjc.2020.10.019. [Google Scholar] [CrossRef]
10. Jayakumar, R., Menon, D., Manzoor, K., Nair, S. V., Tamura, H. (2010). Biomedical applications of chitin and chitosan-based nanomaterials—A short review. Carbohydrate Polymers, 82(2), 227–232. DOI 10.1016/j.carbpol.2010.04.074. [Google Scholar] [CrossRef]
11. Jayakumar, R., Nwe, N., Tokura, S., Tamura, H. (2007). Sulfated chitin and chitosan as novel biomaterials. International Journal of Biological Macromolecules, 40(3), 175–181. DOI 10.1016/j.ijbiomac.2006.06.021. [Google Scholar] [CrossRef]
12. Chandra, A., Turng, L. S., Gopalan, P., Rowell, R. M., Gong, S. (2008). Study of utilizing thin polymer surface coating on the nanoparticles for melt compounding of polycarbonate/alumina nanocomposites and their optical properties. Composites Science and Technology, 68(3–4), 768–776. DOI 10.1016/j.compscitech.2007.08.027. [Google Scholar] [CrossRef]
13. Jeon, I. Y., Baek, J. B. (2010). Nanocomposites derived from polymers and inorganic nanoparticles. Materials, 3(6), 3654–3674. DOI 10.3390/ma3063654. [Google Scholar] [CrossRef]
14. Dallas, P., Sharma, P. K., Zboril, R. (2011). Silver polymeric nanocomposites as advanced antimicrobial agents: Classification, synthetic paths, applications, and perspectives. Advances in Colloid and Interface Science, 166(1–2), 119–135. DOI 10.1016/j.cis.2011.05.008. [Google Scholar] [CrossRef]
15. Lu, Z., Gao, J., He, Q., Wu, J., Liang, H. et al. (2017). Enhanced anti-bacterial and wound healing activities of microporous Chitosan-Ag/ZnO composite dressing. Carbohydrate Polymers, 156(16), 460–469. DOI 10.1016/j.carbpol.2016.09.051. [Google Scholar] [CrossRef]
16. Kumar, S. K., Kumar, V. B., Paik, P. (2013). Recent advancement in functional core-shell nanoparticles of polymers: Synthesis, physical properties, and applications in medical biotechnology. Journal of Nanoparticles, 2013, 1–24. DOI 10.1155/2013/672059. [Google Scholar] [CrossRef]
17. Shukla, S. K., Mishra, A. K., Arotiba, O. A., Mamba, B. B. (2013). Chitosan-based nanomaterials: A state-of-the-art review. International Journal of Biological Macromolecules, 59(8), 46–58. DOI 10.1016/j.ijbiomac.2013.04.043. [Google Scholar] [CrossRef]
18. Mansur, H. S., Mansur, A. A. P., Curti, E., Almeida, M. V. D. (2013). Functionalized-chitosan/quantum dot nano-hybrids for nanomedicine applications: Towards biolabeling and biosorbing phosphate metabolites. Journal of Materials Chemistry B, 1(12), 1696–1711. DOI 10.1039/C3TB00498H. [Google Scholar] [CrossRef]
19. Das, C. G. A., Kumar, V. G., Dhan, T. S., Karthick, V., Govindaraju, K. et al. (2020). Anti-bacterial activity of silver nanoparticles (biosynthesisA short review on recent advances. Biocatalysis and Agricultural Biotechnology, 27(8), 101593. DOI 10.1016/j.bcab.2020.101593. [Google Scholar] [CrossRef]
20. Albrecht, M. A., Evans, C. W., Raston, C. L. (2006). Green chemistry and the health implications of nanoparticles. Green Chemistry, 8(5), 417–432. DOI 10.1039/B517131H. [Google Scholar] [CrossRef]
21. Sharma, V. K., Yngard, R. A., Lin, Y. (2009). Silver nanoparticles: Green synthesis and their antimicrobial activities. Advances in Colloid and Interface Science, 145(1–2), 83–96. DOI 10.1016/j.cis.2008.09.002. [Google Scholar] [CrossRef]
22. Chandra, H., Kumari, P., Bontempi, E., Yadav, S. (2020). Medicinal plants: Treasure trove for green synthesis of metallic nanoparticles and their biomedical applications. Biocatalysis and Agricultural Biotechnology, 24(1), 101518. DOI 10.1016/j.bcab.2020.101518. [Google Scholar] [CrossRef]
23. Ankamwar, B., Damle, C., Ahmad, A., Sastry, M. (2005). Biosynthesis of gold and silver nanoparticles using Emblica Officinalis fruit extract, their phase transfer and transmetallation in an organic solution. Journal of Nanoscience and Nanotechnology, 5(10), 1665–1671. DOI 10.1166/jnn.2005.184. [Google Scholar] [CrossRef]
24. Renuka, R., Devi, K. R., Sivakami, M., Thilagavathi, T., Uthrakumar, R. et al. (2020). Biosynthesis of silver nanoparticles using Phyllanthus emblica fruit extract for antimicrobial application. Biocatalysis and Agricultural Biotechnology, 24(8), 101567. DOI 10.1016/j.bcab.2020.101567. [Google Scholar] [CrossRef]
25. Shenoy, C., Patil, M. B., Kumar, R. (2009). Anti-bacterial and wound healing activity of the leaves of Annona squamosa Linn. (Annonaceae). Research Journal of Pharmacognosy and Phytochemistry, 1(1), 44–50. [Google Scholar]
26. Zahid, M., Mujahid, M., Singh, P. K., Farooqui, S., Singh, K. et al. (2018). Annona squamosa linn. (Custard appleAn aromatic medicinal plant fruit with immense nutraceutical and therapeutic potentials. International Journal of Pharmaceutical Sciences and Research, 9(5), 1745–1759. DOI 10.13040/IJPSR.0975-8232.9(5). 1745-59. [Google Scholar] [CrossRef]
27. Anaya-Esparza, L. M., García-Magaña, M. D. L., Domínguez-Ávila, J. A., Yahia, E. M., Salazar-López, N. J. et al. (2020). Annonas: Underutilized species as a potential source of bioactive compounds. Food Research International, 138(12), 109775. DOI 10.1016/j.foodres.2020.109775. [Google Scholar] [CrossRef]
28. Ismail, A. M., Mohamed, E. A., Marghany, M. R., Abdel-Motaal, F. F., Abdel-Farid, I. B. et al. (2016). Preliminary phytochemical screening, plant growth inhibition and antimicrobial activity studies of Faidherbia albida legume extracts. Journal of the Saudi Society of Agricultural Sciences, 15(2), 112–117. DOI 10.1016/j.jssas.2014.06.002. [Google Scholar] [CrossRef]
29. Gul, R., Jan, S. U., Faridullah, S., Sherani, S., Jahan, N. (2017). Preliminary phytochemical screening, quantitative analysis of alkaloids, and antioxidant activity of crude plant extracts from ephedra intermedia indigenous to balochistan. Scientific World Journal, 2017, 1–7. DOI 10.1155/2017/5873648. [Google Scholar] [CrossRef]
30. Kalidindi, N., Thimmaiah, N. V., Jagadeesh, N. V., Nandeep, R., Swetha, S. et al. (2015). Antifungal and antioxidant activities of organic and aqueous extracts of Annona squamosa Linn. Leaves. Journal of Food and Drug Analysis, 23(4), 795–802. DOI 10.1016/j.jfda.2015.04.012. [Google Scholar] [CrossRef]
31. Ruddaraju, L. K., Pallela, P. N. V. K., Pammi, S. V. N., Padavala, V. S., Kolapalli, V. R. M. (2019). Synergetic anti-bacterial and anticarcinogenic effects of Annona squamosa leaf extract mediated silver nano particles. Materials Science in Semiconductor Processing, 100(1), 301–309. DOI 10.1016/j.mssp.2019.05.007. [Google Scholar] [CrossRef]
32. Al-Nemari, R., Al-Senaidy, A., Semlali, A., Ismael, M., Yacine, A. et al. (2020). GC-MS profiling and assessment of antioxidant, anti-bacterial, and anticancer properties of extracts of Annona squamosa L. leaves. BMC Complementary Medicine and Therapies, 20(1), 1–14. DOI 10.1186/s12906-020-03029-9. [Google Scholar] [CrossRef]
33. Kumar, M., Changan, S., Tomar, M., Prajapati, U., Saurabh, V. et al. (2021). Custard apple (Annona squamosa L.) leaves: Nutritional composition, phytochemical profile, and health-promoting biological activities. Biomolecules, 11(5), 614. DOI 10.3390/biom11050614. [Google Scholar] [CrossRef]
34. Mikhailova, E. O. (2020). Silver nanoparticles: Mechanisms of action and probable bio-application. Journal of Functional Biomaterials, 11(4), 84. DOI 10.3390/jfb11040084. [Google Scholar] [CrossRef]
35. Ansar, S., Tabassum, H., Aladwan, N. S. M., Ali, M. N., Almahrouqi, B. A. S. et al. (2020). Eco friendly silver nanoparticles synthesis by Brassica oleracea and its antibacterial, anticancer and antioxidant properties. Scientific Reports, 10(1), 165. DOI 10.1038/s41598-020-74371-8. [Google Scholar] [CrossRef]
36. Rezazadeh, N. H., Buazar, F., Matroodi, S. (2020). Synergistic effects of combinatorial chitosan and polyphenol biomolecules on enhanced antibacterial activity of biofunctionalized silver nanoparticles. Scientific Reports, 10, 19615. DOI 10.1038/s41598-020-76726-7. [Google Scholar] [CrossRef]
37. Thirunavoukkarasu, M., Balaji, U., Behera, S., Panda, P. K., Mishra, B. K. (2013). Biosynthesis of silver nanoparticle from leaf extract of Desmodium gangeticum (L.) DC. and its biomedical potential. Spectrochimica Acta Part A: Molecular and Biomolecular Spectroscopy, 116(12), 424–427. DOI 10.1016/j.saa.2013.07.033. [Google Scholar] [CrossRef]
38. Raza, S., Ansari, A., Siddiqui, N. N., Ibrahim, F., Ishaque Abro, M. et al. (2021). Biosynthesis of silver nanoparticles for the fabrication of non-cytotoxic and antibacterial metallic polymer-based nanocomposite system. Scientific Reports, 11, 10500. DOI 10.1038/s41598-021-90016-w. [Google Scholar] [CrossRef]
39. Hemlata, Meena, P. R., Singh, A. P., Tejavath, K. K. (2020). Biosynthesis of silver nanoparticles using Cucumis prophetarum aqueous leaf extract and their anti-bacterial and antiproliferative activity against cancer cell lines. ACS Omega, 5(10), 5520–5528. DOI 10.1021/acsomega.0c00155. [Google Scholar] [CrossRef]
40. Ravichandra, S., Paluri, V., Kumar, G., Loganathan, K., Venkata, B. R. K. (2016). A novel approach for the biosynthesis of silver oxide nanoparticles using aqueous leaf extract of Callistemon lanceolatus (Myrtaceae) and their therapeutic potential. Journal of Experimental Nanoscience, 11(6), 445–458. DOI 10.1080/17458080.2015.1077534. [Google Scholar] [CrossRef]
41. Ali, M. A., Mosa, K. A., El-keblawy, A., Alawadhi, H. (2019). Exogenous production of silver nanoparticles by Tephrosia apollinea living plant under drought stress and their antimicrobial activities. Nanomaterials, 9(12), 1–13. DOI 10.3390/nano9121716. [Google Scholar] [CrossRef]
42. Salehi, S., Shandiz, S. A. S., Ghanbar, F., Darvish, M. R., Ardestain, M. S. et al. (2016). Phytosynthesis of silver nanoparticles using Artemisia marschalliana Sprengel aerial part extract and assessment of their antioxidant, anticancer and anti-bacterial properties. International Journal of Nanomedicine, 11, 1835–1846. DOI 10.2147/IJN.S99882. [Google Scholar] [CrossRef]
43. Oliveira, G. Z., Lopes, C. A., Sousa, M. H., Silva, L. P. (2019). Synthesis of silver nanoparticles using aqueous extracts of Pterodonemarginatus leaves collected in the summer and winter seasons. International Nano Letter, 9(2), 109–117. DOI 10.1007/s40089-019-0265-7. [Google Scholar] [CrossRef]
44. Gudikandula, K., Maringanti, S. C. (2016). Synthesis of silver nanoparticles by chemical and biological methods and their antimicrobial properties. Journal of Experimental Nanoscience, 11(9), 714–721. DOI 10.1080/17458080.2016.1139196. [Google Scholar] [CrossRef]
45. Jyoti, K., Baunthiyal, M., Singh, A. (2016). Characterization of silver nanoparticles synthesized using Urtica dioica Linn. leaves and their synergistic effects with antibiotics. Journal of Radiation Research and Applied Sciences, 9(3), 217–227. DOI 10.1016/j.jrras.2015.10.002. [Google Scholar] [CrossRef]
46. Narayanan, M., Divya, S., Natarajan, D., Senthil-Nathan, S., Kandasamy, S. et al. (2021). Green synthesis of silver nanoparticles from aqueous extract of Ctenolepis garcinia L. and assess their possible biological applications. Process Biochemistry, 107(8), 91–99. DOI 10.1016/j.procbio.2021.05.008. [Google Scholar] [CrossRef]
47. Lee, S. H., Jun, B. H. (2019). Silver nanoparticles: Synthesis and application for nanomedicine. International Journal of Molecular Sciences, 20(4), 1–24. DOI 10.3390/ijms20040865. [Google Scholar] [CrossRef]
48. Dawad, S., Katuwa, S., Gupta, A., Lamichhane, U., Thapa, R. et al. (2021). Current research on silver nanoparticles: Synthesis, characterization, and applications. Journal of Nanomaterials, 2021, 1–23. DOI 10.1155/2021/6687290. [Google Scholar] [CrossRef]
49. Morsi, R. E., Alsabagh, A. M., Nasr, S. A., Zaki, M. M. (2017). Multifunctional nanocomposites of chitosan, silver nanoparticles, copper nanoparticles and carbon nanotubes for water treatment: Antimicrobial characteristics. International Journal of Biological Macromolecules, 97(4), 264–269. DOI 10.1016/j.ijbiomac.2017.01.032. [Google Scholar] [CrossRef]
50. Klueh, U., Wanger, V., Kelly, S., Johnson, A., Bryers, J. D. (2000). Efficacy of silver-coated fabric to prevent bacterial colonization and subsequent device-based biofilm formation. Journal of Biomedical Materials Research, 56(6), 621–631. DOI 10.1002/1097-4636(2000)53:63.0.CO;2-Q. [Google Scholar] [CrossRef]
51. Prabhu, S., Poulose, E. K. (2012). Silver nanoparticles: Mechanism of antimicrobial action, synthesis, medical applications, and toxicity effects. International Nano Letters, 2(1), 398. DOI 10.1186/2228-5326-2-32. [Google Scholar] [CrossRef]
52. Dakal, T. C., Kumar, A., Majumdar, R. S., Yadav, V. (2016). Mechanistic basis of antimicrobial actions of silver nanoparticles. Frontiers in Microbiology, 7, 720654. DOI 10.3389/fmicb.2016.01831. [Google Scholar] [CrossRef]
53. Yan, X., He, B., Liu, L., Qu, G., Shi, J. et al. (2018). Anti-bacterial mechanism of silver nanoparticles in Pseudomonas aeruginosa: Proteomics approach. Metallomics, 10(4), 557–564. DOI 10.1039/C7MT00328E. [Google Scholar] [CrossRef]
54. Yin, I. X., Zhang, J., Zhao, I. S., Mei, M. L., Li, Q. et al. (2020). The antibacterial mechanism of silver nanoparticles and its application in dentistry. International Journal of Nanomedicine, 15, 2555–2562. DOI 10.2147/IJN.S246764. [Google Scholar] [CrossRef]
55. Syed, A. A., Sabya, S. D., Ayesha, K., Mohammed, T. A., Mohd, A. et al. (2020). Bactericidal activity of silver nanoparticles: A mechanistic review. Materials Science for Energy Technologies, 3(20), 756–769. DOI 10.1016/j.mset.2020.09.002. [Google Scholar] [CrossRef]
56. Chabattula, S. C., Gupta, P. K., Tripathi, S. K., Gahtori, R., Padhi, P. et al. (2021). Anticancer therapeutic efficacy of biogenic Am-ZnO nanoparticles on 2D and 3D tumor models. Materials Today Chemistry, 22(6), 100618. DOI 10.1016/j.mtchem.2021.100618. [Google Scholar] [CrossRef]
![]() | This work is licensed under a Creative Commons Attribution 4.0 International License, which permits unrestricted use, distribution, and reproduction in any medium, provided the original work is properly cited. |